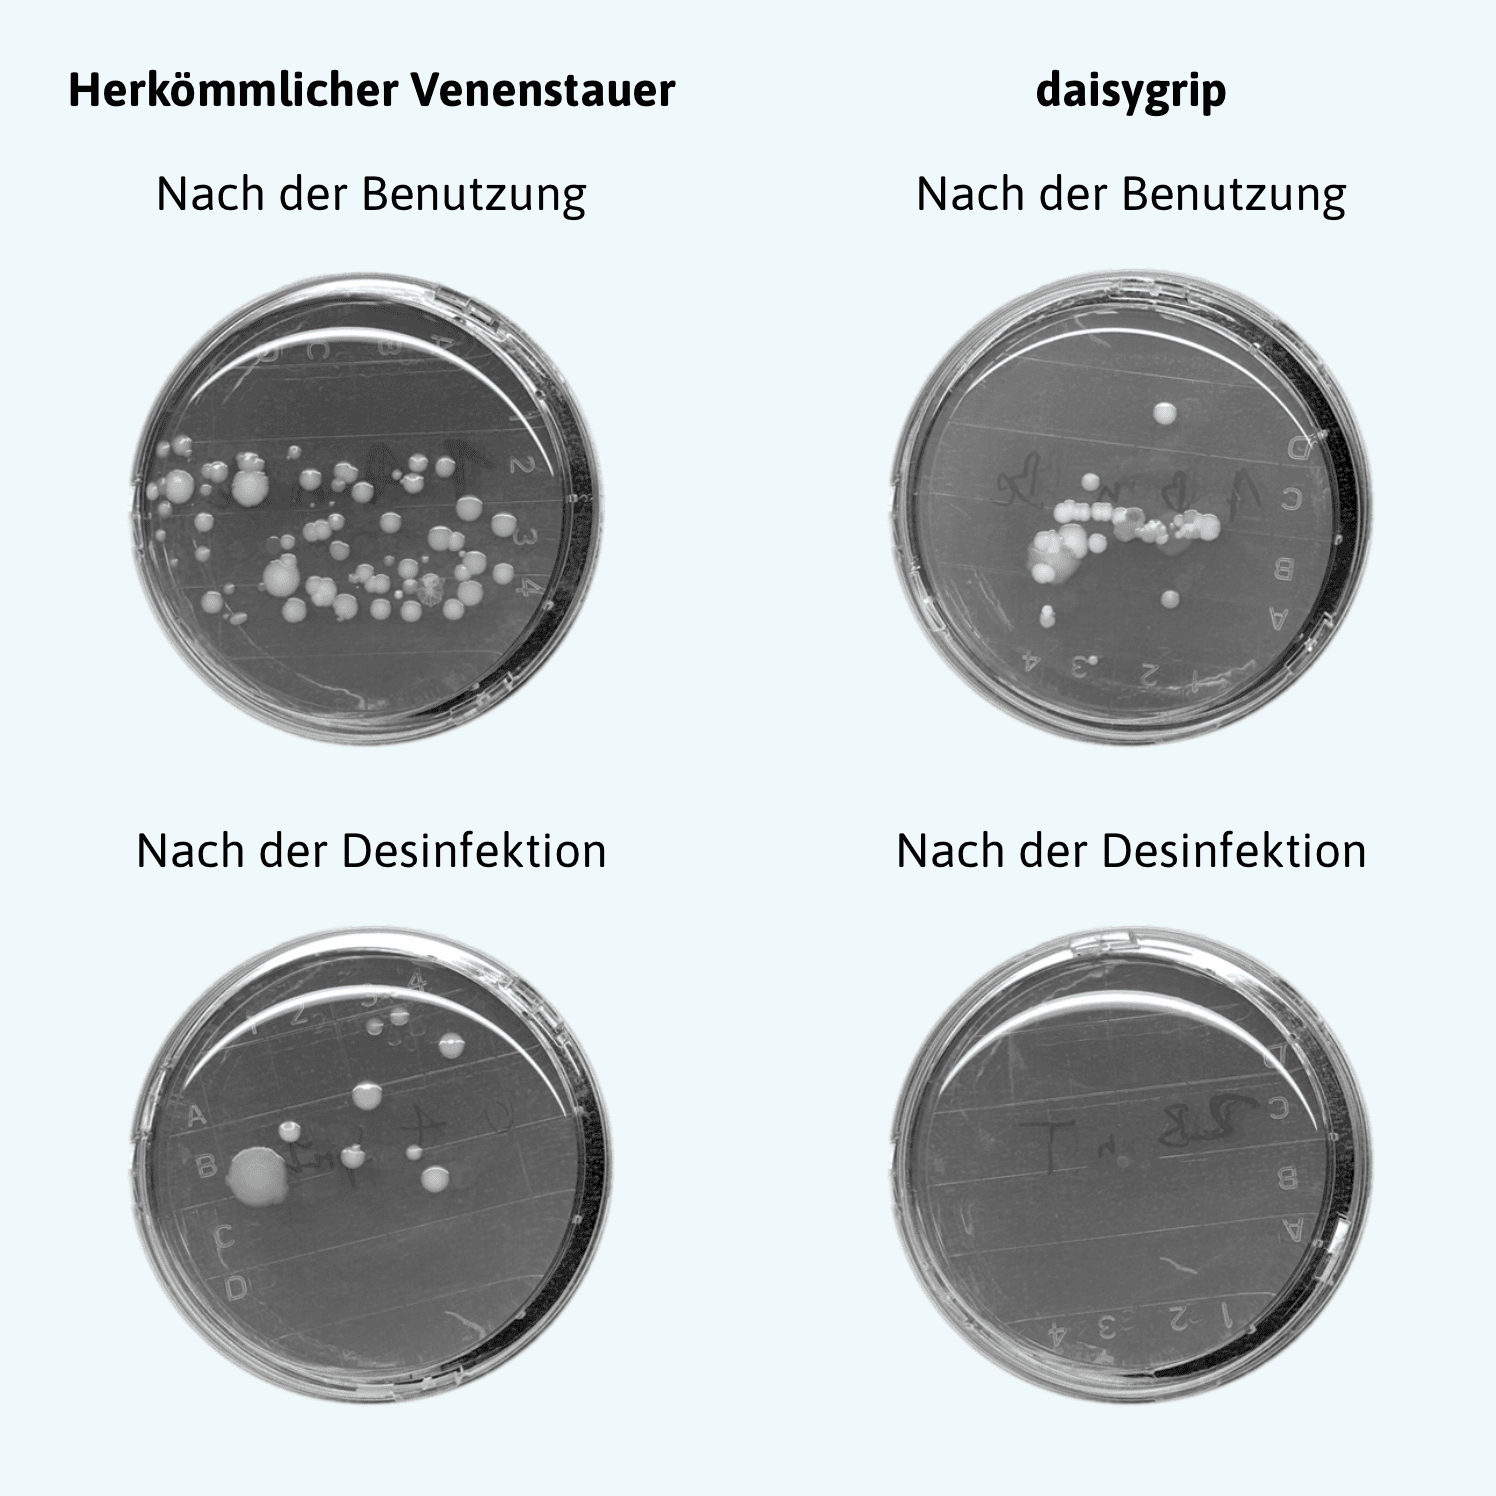

Mikrobiologische Testungen des daisygrip
Die Desinfektion von Silikon-Venenstauern ist im klinischen Alltag wirksam:
Der daisygrip ist die sichere Alternative zu herkömmlichen Stauschläuchen und den mit ihrer Nutzung verbundenen Risiken.
Dank des innovativen Materials lässt sich der Venenstauer in Sekundenschnelle durch eine einfache Wischdesinfektion zuverlässig am Point-of-Care reinigen – für mikrobiologisch getestete Hygiene nach jedem Einsatz.
Die Überlegenheit dieses Konzepts wurde in In-vitro-Versuchen sowie in einer unabhängigen Studie mehrfach belegt und unter anderem im renommierten BMC Infectious Diseases Journal veröffentlicht.
Der Schlüssel: Die einfache Wischdesinfektion aller Oberflächen des daisygrip:
- Der selbstfindende Magnetverschluss lässt sich sowohl mühelos mit einer Hand öffnen UND schließen als auch zuverlässig reinigen.
- Das Silikonband kann in Sekunden gereinigt und aufbereitet werden.
- Anschließend ist der daisygrip umgehend wieder einsatzbereit und kann bedenkenlos am nächsten Patienten eingesetzt werden.
Der daisygrip sorgt so für mehr Sicherheit und reduziert Kosten, Zeit- und Arbeitsaufwand.